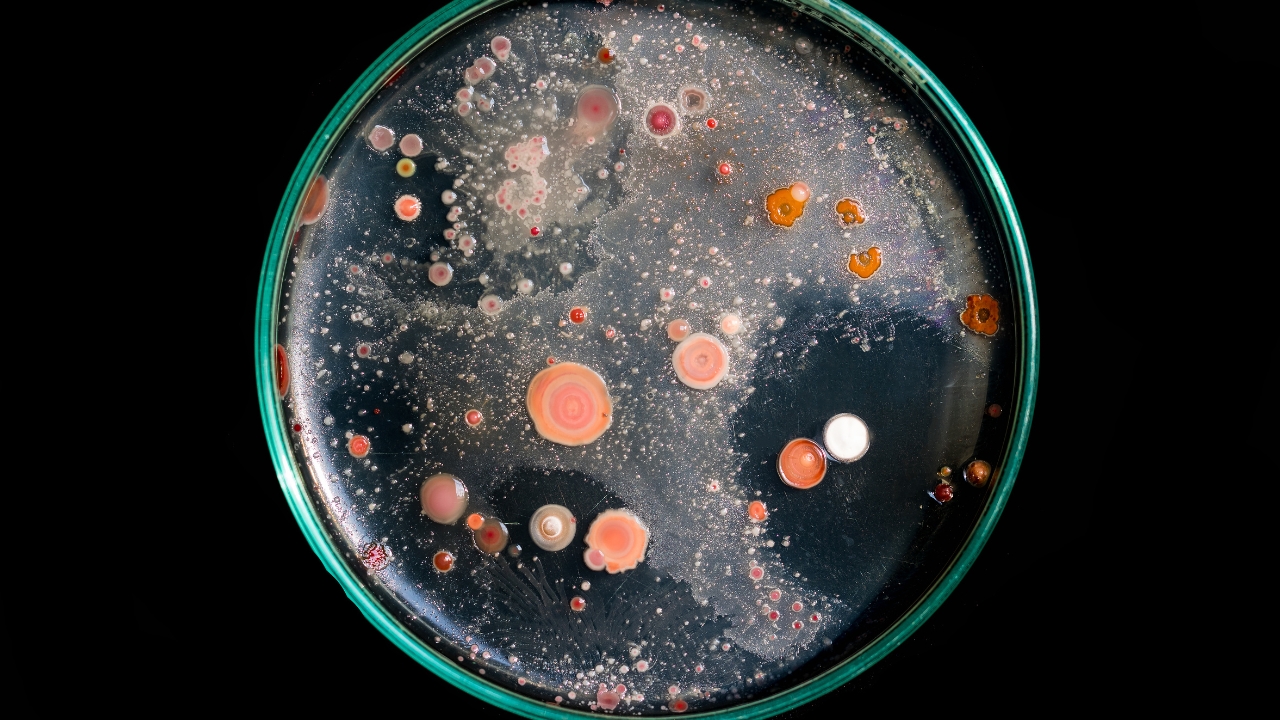

Why your $2 dish soap might be making your sink smell worse
Most people don’t realize that the dish soap they buy can play a big role in how their kitchen sink smells. A $2 bottle might get suds going, but cheaper formulas often leave behind buildup that makes odors worse over time. When grease, food particles, and leftover soap mix in the drain, they create the perfect environment for that sour smell you can’t quite get rid of.
If your sink keeps stinking no matter how much you scrub, your soap could be part of the problem. Here’s what to watch for and what to do differently.
Too Much Fragrance, Not Enough Cleaning Power

Budget dish soaps often load up on fragrance to cover their weaker formulas. While your dishes might smell fresh at first, the residue left behind can collect in the sink and turn sour fast.
Stronger soaps cut through grease instead of masking it, so you’re not left with hidden grime that ferments later. Choosing a soap that actually removes buildup instead of covering it up makes a noticeable difference.
Thicker Doesn’t Mean Stronger

Some cheaper dish soaps feel thick and foamy, but that doesn’t always mean they’re cleaning well. A lot of the thickness comes from fillers, not grease-fighting ingredients.
This can leave behind a film in your sink that traps food particles. Over time, that film starts to smell, and you’ll find yourself scrubbing your sink more often than necessary.
Food Particles Stick to Soap Residue

When soap doesn’t rinse clean, it leaves a sticky coating in the drain. That coating is a magnet for small food particles that slip through the strainer.
Those scraps don’t just disappear—they sit and break down, which is where the stink comes from. A better soap rinses fully so nothing lingers to rot in your drain.
Diluted Formulas Waste More Product

A $2 soap might seem like a bargain, but many budget formulas are watered down. That means you need to use more to get the same effect.
Using extra soap not only empties your bottle faster but also leaves more residue behind. In the long run, it costs more and contributes to the smell problem.
Cheap Soaps Don’t Always Kill Bacteria
Many low-cost dish soaps aren’t designed to target the bacteria that grow in sinks and drains. They’ll remove grease but won’t stop germs from multiplying.
That bacteria is what makes the smell linger, even after you’ve cleaned. A higher-quality soap or a disinfecting rinse helps control the odor at its source.
Grease Buildup Spreads to the Drain

If your soap can’t cut through grease, it ends up sliding into your drain instead. There, it sticks to the sides of the pipes and catches everything else that passes through.
Grease in the drain is one of the fastest ways to get a foul smell in the kitchen. A stronger formula keeps grease from ever reaching that point.
Masking Odors With Lemon Scents Doesn’t Work

Lemon-scented dish soap is a common choice when people want their sink to smell fresh. The problem is, the scent only covers odors for a short time.
Once the soap residue mixes with food waste, the smell gets even worse because the sour notes combine with rotting particles. Real cleaning beats fake freshness every time.
You Scrub More Than You Should
When soap doesn’t do its job, you end up scrubbing your sink constantly to fight the smells. The extra scrubbing doesn’t fix the root problem—it just temporarily hides it.
A soap that actually removes grease and bacteria makes sink cleaning easier and less frequent. It also keeps the drain from developing that musty odor in the first place.
Hidden Fillers Leave a Film

Cheap dish soaps often contain fillers that don’t serve any cleaning purpose. These ingredients make the soap look thicker or foamier without adding real effectiveness.
That film stays behind in your sink, especially around the drain area. It’s an invisible layer that traps grime and turns into odor within days.
Spending a Little More Saves You in the Long Run

While a $2 soap seems like the frugal option, the extra scrubbing, wasted product, and odor problems end up costing you more time and money.
Spending a couple of extra dollars on a soap that actually works reduces buildup, keeps your sink fresher, and makes cleaning easier. Sometimes, the cheapest option isn’t really saving you at all.
*This article was developed with AI-powered tools and has been carefully reviewed by our editors.
